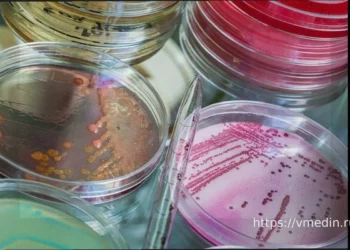
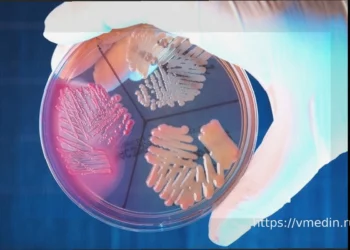

Интерес к дыхательным тренажерам неуклонно растет. Производители заявляют о множестве преимуществ: от увеличения выносливости и силы вдоха у спортсменов до облегчения одышки у пожилых людей. Однако стоит отметить, что обещания о подтяжке овала лица относятся скорее к сфере маркетинга и не имеют научного подтверждения. В то же время, другие заявленные эффекты действительно основаны на серьезных исследованиях.
Что это такое?
Дыхательный тренажер с сопротивлением представляет собой компактное приспособление, которое создает препятствие для вдоха, а иногда и для выдоха. При использовании такого тренажера диафрагма и межреберные мышцы вынуждены работать с усилием, подобным подъему веса, что приводит к их укреплению по аналогии с тренировкой других мышц тела.
Результаты исследований
Научные данные подтверждают эффективность дыхательных тренажеров. В октябре 2025 года в издании Respiratory Physiology & Neurobiology были опубликованы результаты египетского исследования, в котором приняли участие 90 пациентов в возрасте 50–70 лет с острой дыхательной недостаточностью на фоне ХОБЛ, находящихся на искусственной вентиляции легких. Участники были разделены на три группы: одна тренировалась с использованием порогового тренажера Threshold IMT, вторая — за счет регулирования чувствительности триггера аппарата ИВЛ, а третья служила контрольной. Исследование показало, что тренировки с постоянным сопротивлением обеспечили наибольший прирост мощности дыхательных мышц.
Еще одно исследование, проведенное в Турции и опубликованное в марте 2025 года в журнале Frontiers in Physiology, включало 22 добровольца. В течение пяти недель они трижды в неделю использовали тренажер с сопротивлением, составляющим 50% от их максимального давления вдоха. Было установлено, что включение дыхательного тренажера в программу тренировок значительно улучшило силу дыхательных мышц и повысило общую физическую выносливость.
Принцип действия
Создаваемое сопротивление при вдохе стимулирует более интенсивное сокращение диафрагмы и межреберных мышц. Это приводит к их укреплению, увеличению объема легких и, как следствие, к более эффективной доставке кислорода ко всем тканям организма. Для пациентов с ослабленной дыхательной системой это может означать восстановление способности к самостоятельному дыханию, а для спортсменов — повышение выносливости и ускоренное восстановление после нагрузок.
- Начинайте тренировки с сопротивлением, составляющим 30–60% от вашего максимального давления вдоха. Этот уровень считается безопасным и достаточным для эффективного укрепления мышц.
- Для спортсменов рекомендовано три занятия в неделю. В то время как для ослабленных пациентов, согласно исследованиям, оптимальны ежедневные тренировки.
- Длительность одной тренировочной сессии должна составлять от 15 до 30 минут.
Таким образом, дыхательный тренажер с сопротивлением не является универсальным решением всех проблем и, безусловно, не предназначен для коррекции овала лица. Тем не менее, это доказанный современными исследованиями эффективный метод для укрепления дыхательных мышц. Он особенно рекомендован пожилым людям с ослабленным дыханием, пациентам в период восстановления после заболеваний, а также спортсменам, стремящимся улучшить свои результаты.